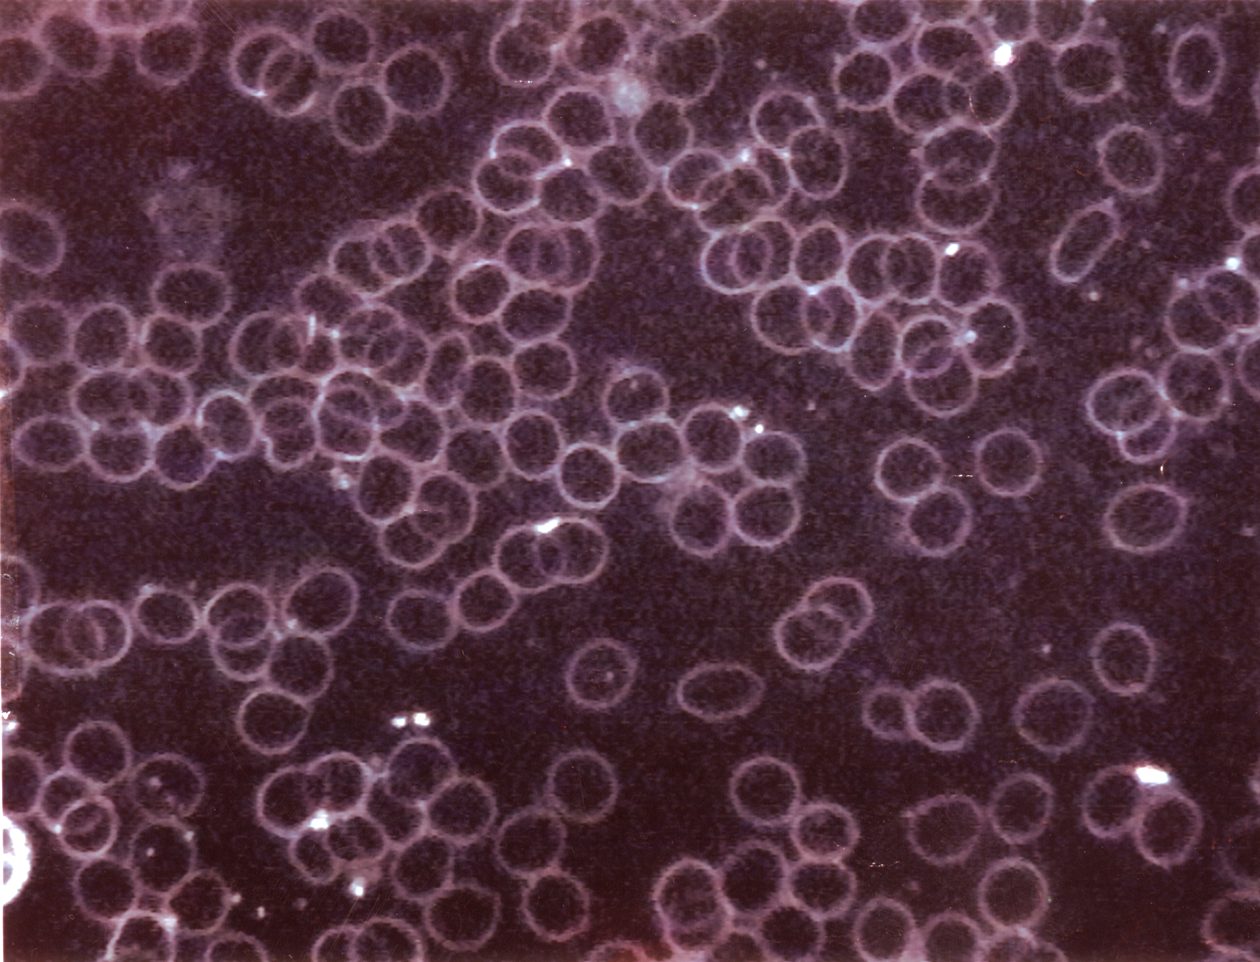

RadiTech Research
Research has shown how effectively the RadiTech works to improve your health.
Picture A. Before

Picture B. After
Unclustered Blood Cells
Picture A shows how clustered red blood cells were when Steve was Geopathic Stressed. By placing his hands and feet on a RadiTech for 15 minutes, Picture B shows Steve’s red blood cells became even and unclustered. Free moving red blood cells transfer more oxygen through the capillaries, preventing accumulation of toxins, infection and long-term damage to the tissues. Certain sticky cells may adhere more easily to the blood vessel walls and may cause arteriosclerosis and a host of other adverse affects.
Thermograph pictures
Part of the body would show up in red colour (too hot) where a Geopathic Stress line crosses a person, when in bed. After the person has become Geopathic Stress free by installing a RadiTech the thermograph pictures would show the body back to normal colour all over.